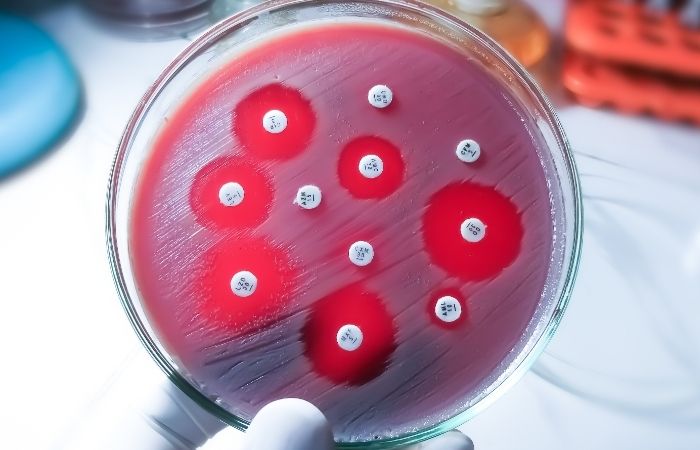

Quick Answer: Testing positive after antibiotics doesn’t always mean you got reinfected, dead bacterial DNA, test timing, partner status, or antibiotic resistance can cause lingering positive results even after successful treatment.
When the Results Don’t Match the Reality
Janelle, 29, had finished her full course of antibiotics for chlamydia. She followed every direction, abstained from sex, and waited the recommended time before retesting. When her follow-up test came back positive, she stared at the screen in disbelief.
“I didn’t even have sex again. I cried. I thought something was seriously wrong with me.”
Stories like Janelle’s aren’t rare, and they’re not caused by carelessness. There are a few key reasons why someone might continue to test positive after treatment, and they have nothing to do with "irresponsibility" or "dirty habits." Instead, the explanation often lies in test types, timing, partner factors, or microbiology most of us aren’t taught.

People are also reading: She Thought I Cheated. I Had No Symptoms. It Was Chlamydia.
Dead Doesn’t Always Mean Gone: Residual DNA in Testing
One of the most misunderstood aspects of STD testing is how long traces of the infection can linger in your body. Specifically, some tests, especially NAAT (nucleic acid amplification tests), are so sensitive that they can detect fragments of the bacteria or parasite even after it’s been killed by antibiotics.
This is particularly true for chlamydia and gonorrhea. You might be cured, but your body hasn’t fully flushed out the genetic material yet. That’s why the CDC recommends waiting at least 3 weeks after treatment to retest for cure, any earlier and you risk catching a false positive from dead DNA.
It's not a treatment failure, it's a test sensitivity issue. And for someone already battling anxiety or stigma, that false alarm can feel like a nightmare. That’s why understanding timing is everything.
When to Retest: Timing Matters More Than You Think
If you test too early, you might be picking up residual traces. But if you wait too long, and you've had sex again, reinfection becomes a real possibility, especially if your partner wasn’t tested or treated alongside you.
| STD | Wait Time Before Retest (CDC) | Why It Matters |
|---|---|---|
| Chlamydia | 3 weeks post-treatment | NAAT tests can detect dead DNA before that |
| Gonorrhea | 7–14 days post-treatment | False positives possible within first 7 days |
| Trichomoniasis | Up to 14 days | Retest at 2 weeks for women (per CDC) |
Figure 1. Recommended retesting windows post-treatment. Testing too early can produce misleading positives due to leftover genetic material.
Knowing these windows can help you avoid panic and unnecessary retreatment. But test timing is just one piece of the puzzle, next, we’ll look at what happens when a partner wasn’t treated at all.
Could Your Partner Be the Problem (Without Knowing It)?
Here’s the raw truth: If you were treated and your partner wasn’t, you’re at major risk of catching the infection again, even if they had no symptoms. In fact, most people with chlamydia or gonorrhea don’t feel a thing and assume they’re clean.
So if they skip the test, or think one negative urine test is enough without checking the right site (like throat or rectum), they could still be carrying the infection and pass it right back to you. It’s not sabotage. It’s medical miscommunication.
This is where partner testing and treatment comes in. The CDC recommends that partners of people diagnosed with bacterial STDs be treated empirically, meaning even without testing, just to stop the cycle.
When Treatment Doesn’t Fully Work (Yes, It Happens)
Sometimes the antibiotics don’t do what they’re supposed to. That doesn’t mean you did anything wrong, it just means that treatment isn’t always a one-size-fits-all solution. With trichomoniasis, for example, as many as 1 in 5 people may require a second round of medication, especially if they were initially given the standard one-day dose instead of a longer regimen.
For gonorrhea, antibiotic resistance is now a global concern. The World Health Organization reports that drug-resistant gonorrhea strains are spreading, and in some cases, the bacteria is becoming harder to treat using first-line medications. If your infection didn’t fully clear, you may still test positive, or worse, experience lingering symptoms without knowing the bacteria is fighting back.
That’s why retesting isn’t about overreacting, it’s about confirming that your body actually responded to treatment, especially if you’re still experiencing symptoms like discharge, pain, or irritation.
Check Your STD Status in Minutes
Test at Home with Remedium7-in-1 STD Test Kit

Order Now $129.00 $343.00
For all 7 tests
Still Feeling Symptoms? It Might Not Be a Return
Repeat symptoms don’t always mean the STD is back. Your body can take time to heal even after the infection is gone. Irritation from the initial infection, inflammation, or even anxiety-fueled hyperawareness can all make it feel like the STD never left.
Niko, 32, tested positive for gonorrhea, took the injection, and waited. But the urethral burn stuck around for days. He kept checking himself in the mirror, convinced he hadn’t healed.
“I swore it came back. But my doctor told me my body was just still recovering, it wasn’t the infection, it was the aftermath.”
Doctors often refer to this as “post-infectious urethritis” or “vaginal dysbiosis”, your tissues need to rebalance. No active STD. No reinfection. Just healing. And for people with vaginas, antibiotics can disrupt the natural flora, making yeast infections or bacterial vaginosis flare up, symptoms that mimic STDs, but aren’t sexually transmitted.
False Positives: Yes, They’re Real
It's not talked about often enough: false positives. While they are rare events, they do occur, especially if high sensitivity tests such as NAAT have been done or have resulted from improper use of home testing kits. It's not just residual DNA at stake: cross-reaction, contamination, or even lab errors become culprits too.
This is why context is so important. A secondary positive result without new sexual exposure, symptoms, or appropriate treatment is a time to raise questions, not answers. Follow-up testing may or may not be necessary, or even testing at another site (such as oral or rectal testing if exposure occurred but wasn’t checked at initial testing).
When you’re unsure of anything, don’t hesitate to contact a telemedicine professional or center knowledgeable about sexual health complexities. And most importantly: You’re not alone, and you’re certainly not “dirty” for seeking information!
At STD Rapid Test Kits, we deliver quick and discreet solutions for situations where you need to have answers without shame. It does not matter whether it is your first or your follow-up test because at all times, having peace of mind is priceless.
What About Antibiotic Resistance?
But gonorrhea is just the front runner for antibiotic resistance, because Mycoplasma genitalium is also starting to seem resistant to azithromycin treatment, even though it is just a sexually transmitted disease that is not very well recognized yet. And even though chlamydia is still very treatable with doxycyline or azithromycin, difficulties with absorption or just missing medication may cause problems for some patients.
This doesn’t mean antibiotics are failing across the board, it just means vigilance matters. Always finish your prescription, avoid sex until treatment is fully completed, and retest at the right time, not too early, not too late. If symptoms persist, a new course of antibiotics or a different drug class may be needed.
Take back your power. Testing again isn’t admitting defeat, it’s protecting yourself and your partners.
People are also reading: Can You Have an STD Without Knowing It?
Shame Is Not a Symptom, But It Feels Like One
The emotional toll of repeat STD diagnoses or lingering positives can be brutal. Not because of the infection itself, but because of what people think it says about you. Even healthcare providers, friends, or partners may (wrongly) assume you’re being careless, cheating, or ignoring medical advice.
But STDs aren’t morality tests. They’re infections. And they behave like infections, sometimes clearing easily, sometimes requiring a second round, sometimes hiding in asymptomatic partners. Feeling ashamed doesn’t make you cleaner or smarter. It just makes it harder to seek help again.
Mari, 26, broke down in the clinic hallway when her trichomoniasis test came back positive after a second round of antibiotics.
“I kept thinking, ‘What’s wrong with me? Why does it keep coming back?’”
Her provider finally explained that her partner never got treated, he had no symptoms, so he assumed he was fine. That’s not a personal failure. That’s a system problem. Testing and treatment must happen in pairs. You can't heal in isolation from the people you're sexually connected to.
Let’s Talk About Your Partner, Without Blame
If you’re dealing with a repeat positive, ask yourself: was your partner tested and treated at the same time as you? Did they complete treatment? Were the right sites tested (oral, vaginal, anal)? Did either of you have other partners in the window since treatment?
This isn’t about blame, it’s about biology. STDs don’t care about intentions. They transmit through contact, not character.
Many people unknowingly carry STDs like chlamydia or gonorrhea in their throat or rectum without symptoms. If those areas weren’t swabbed during the original test, the infection may have been missed entirely.
And if your partner didn’t test or treat, or just assumed one pill fixed everything, you may be caught in a reinfection loop.
| Scenario | Risk of Reinfection | What to Do |
|---|---|---|
| Partner didn’t get tested or treated | Very high | Assume treatment is needed; use partner-delivered therapy if possible |
| Throat or rectal sites weren’t tested | High (if exposure occurred) | Request extra-genital testing or use combo test kits that include swabs |
| Partner treated but resumed sex too soon | Moderate | Wait full treatment window before resuming sexual activity |
| False belief that a condom prevented all risk | Moderate | STDs like herpes and HPV spread via skin contact, use full protection & testing |
Figure 2. Common partner-related reinfection scenarios and action steps.
What If You’ve Done Everything Right?
You may have done everything right, talked to your partners, and waited the right amount of time, but the test still won't turn negative. That's when you should take a step back and think about things that aren't as common, like:
- Biofilms: Some bacteria make sticky layers around themselves to keep treatments from working.
- Misdiagnosis: Your symptoms could be caused by something else, and the tests found an infection that wasn't the cause.
- Mistake in testing: Results can be wrong if the samples are dirty, the lab makes a mistake, or the swab is done wrong.
- Co-infection: This means you may have more than one STD, which can make symptoms worse or make them take longer to go away.
If this sounds like you, it's a good idea to get a second opinion or try a different kind of test, like a lab-based NAAT instead of a quick test. Depending on how comfortable, private, and urgent you need to be, STD Rapid Test Kits has both quick and mail-in options.
Your Next Test Should Be Empowering, Not Fearful
When your first result is confusing or different from what you know to be your reality, your nagging feeling may want to just avoid testing all together. But here is the truth: testing may just be the most powerful thing you can do because you trust your body enough to go back and verify your result.
However, if you’re still unsure, go ahead and use a personal home lab-quality test for multiple infections such as oral and anal exposure to infections right now.
Check Your STD Status in Minutes
Test at Home with Remedium8-in-1 STD Test Kit

Order Now $149.00 $392.00
For all 8 tests
FAQs
1. Can I still test positive even after finishing antibiotics?
Yeah, but it wouldn’t mean that the meds weren’t effective. It's just that some chlamydia tests may retain traces of DNA even after the chlamydia is cleared from your system. Like footprints left behind by a burglar after he's been caught, but your system is rid of all signs of trouble while traces remain for testing.
2. How long should I wait to test again after treatment?
Patience is annoying, but powerful. For chlamydia, you’ll want to wait at least three weeks before retesting, same for trich. For gonorrhea, give it about a week or two. Testing too early can mess with your results and your peace of mind. Let your body clear the wreckage before checking the scene again.
3. What if I haven’t had sex again, so how could I have it again?
This is one of the most common and most heartbreaking questions. If you haven’t had sex since treatment and you’re testing positive again, it’s probably not a “you” thing. It could be leftover DNA, a partner who never got treated, or even a testing issue. You’re not imagining it, something real is happening, but it’s not your fault.
4. My partner says they’re fine. Should I still ask them to test?
Yes. With love, yes. Many STDs are totally silent, especially in men. That “I feel fine” logic doesn’t hold up under a microscope. Testing isn’t an accusation, it’s a team sport. You both deserve to know what’s really going on.
5. What if my symptoms came back, but the test is negative now?
You could be dealing with post-infection irritation (which is common), another condition like BV or a yeast imbalance, or the test may have missed an infection site. If your body's still whispering (or screaming), listen. Follow up, retest, and advocate for site-specific swabs if exposure happened orally or anally.
6. Could the treatment have just... not worked?
It happens. Sometimes the bacteria fight back. Sometimes your body doesn't absorb the meds fully. Sometimes the one-pill protocol isn’t enough (looking at you, trich). If you're still feeling off after the treatment window, circle back with a provider. You might need a second round, or a different med entirely.
7. Are false positives even real, or is that just wishful thinking?
They’re real, especially when tests are done too early or used incorrectly. NAATs are great, but they’re also drama queens, picking up the tiniest bits of DNA. If you’re shocked by a repeat positive with no new exposure and no symptoms, ask for confirmatory testing. You’re allowed to question things.
8. Do condoms prevent reinfection completely?
Condoms are amazing, but they’re not magic shields. They don’t cover everything. STDs like herpes or HPV can spread via skin-to-skin contact outside the condom zone. Also, if the infection’s in the throat or rectum and those areas weren’t tested or protected, it can sneak through. Use them, but don’t stop at them.
9. What if I did everything right, and I still got it again?
First of all, deep breath. Second: doing “everything right” doesn’t guarantee immunity. Life is messy. Partners forget to test. Infections hide. Biology is sneaky. What matters is that you’re paying attention, getting tested, and staying informed.
10. Is it okay to test at home again instead of going back to the clinic?
Totally okay. Just make sure to use a good FDA-approved kit (such as this combo kit) and stick to the timeline guidelines. At home testing is discreet, easy to use, and effective if done properly. And let's be honest—you just want to avoid the waiting room. We don't blame you. We get it.
You’re Not Alone, And You’re Not Broken
If you’re still testing positive after antibiotics, you’re not cursed, careless, or doomed to repeat. You’re navigating a complex system with real gaps, in partner care, test timing, and public understanding.
This isn’t about blame. It’s about biology, behavior, and being human. Whether you’re seeking clarity, closure, or control, there’s no shame in retesting, and no harm in wanting certainty.
Don’t guess. Don’t spiral. This combo STD test kit gives you answers without judgment, because you deserve peace of mind, not paranoia.
How We Sourced This Article: We combined current guidance from leading medical organizations with peer-reviewed research and lived-experience reporting to make this guide practical, compassionate, and accurate. In total, around fifteen references informed the writing; below, we’ve highlighted some of the most relevant and reader-friendly sources.
Sources
1. CDC – 2021 STD Treatment Guidelines
2. WHO – STIs and Antibiotic Resistance
3. Retesting After Treatment to Detect Repeat Infections | CDC
4. Chlamydia treatment failed twice: Why and next steps | Medical News Today
5. Yes, Chlamydia Can ‘Come Back’ — Here’s How to Prevent It | Healthline
About the Author
Dr. F. David, MD is a board-certified infectious disease specialist focused on STI prevention, diagnosis, and treatment. He blends clinical precision with a no-nonsense, sex-positive approach and is committed to expanding access for readers in both urban and off-grid settings.
Reviewed by: A. Singh, MPH | Last medically reviewed: November 2025
This article is for informational purposes and does not replace medical advice.





